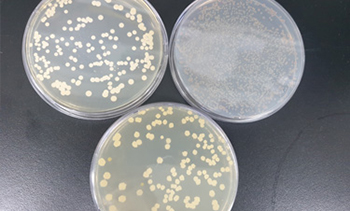

액상미생물배양실
- 시설연도 : 2016년
- 시설면적 : 466.8㎡
- 생산품목 : 광합성균, 고초균, 유산균, 효모, 순천시 특허균, 비티제
- 주요장비 : 배양기 13대, 자동포장기 2대, 인큐베이터 8대, 실험용 초저온냉동고 2대 등

순천시 액상 미생물제제 특징
| 미생물 종류 | 특성 | 작용 및 활용 | 비고 |
|---|---|---|---|
| 고초균 | -막대기 모양으로 유기물 분해 능력이 매우 우수하고 배양이 쉽고 토양내의 대표적인 미생물 -극한조건에서 죽지 않는 포자형성 |
-식물지하부 생육기능 -향균효과가 매우 커 작물 병해 억제 효과가 탁월 |
파리등 유충 구제 |
| 유산균 | -공기가 없는 상태에서 잘 자라는 혐기성 세균으로 배양시 젖산분비 -토양 유기물을 분해하면서 고급 영양소와 다양한 기능성 물질 합성 |
-뿌리의 발근 촉진 -토양내의 비료성분의 유효도를 높이는 기능이 탁월함 |
|
| 효모 | -쌀겨, 밀기울 등 농가부산물의 고체 발효할 때 주요 미생물로서 유기물 분해 능력이 뛰어남 | -쌀겨에 효모를 넣고 토양개량제로 사용하면 효과적 -토마토 재배시 효모 배양액을 살포하면 토마토내의 항산화 물질 인라이 코펜의 함량이 160% 증가 |
식물잔사등 부숙 |
| 광합성균 | -보조사료 중 생균제 등록 가능 세균 -가축의 장내에서 발생하는 유해 가스나 분뇨의 악취 물질인 탄산, 질소, 유황 화합물의 악취 가스를 먹이로 활용 |
-악취제거 및 유해가스 제거 -가축의 장내 유익미생물 증식을 통한 병원성 미생물 제거 또는 경감 |
|
| BT제 | -안전성이 검증된 유기농업자재 -BT제를 먹은 유충은 장기패 혈증을 유발하여 죽음 |
-대상작물(고추,배추,토마토등) -배추좀나방, 파밤나방, 이화명나방, 혹명나방 등 나방류에 대한 살충 효과가 있으며 포유류등 다른 생물에는 독성이 없음 |
실험실 미생물 현미경 관찰 및 생균수 측정
![]() |
![]() |
![]() |
![]() |
![]() |
![]() |
고형유용미생물 생산시설
- 시설연도 : 2014년
- 시설면적 : 499.38㎡
- 생산품목 : 펠릿형 토양미생물제제, 분말형 보조사료
- 장 비 : 발효기 2대, 펠릿성형기 1대, 배합기 1대, 포장기 2대 등

순천시 고형 미생물제제 특징
| 미생물 종류 | 사용효과 | 사용방법 | 비고 |
|---|---|---|---|
| 분말형보조사료(생균제) |
-사료효율 및 기호성증진 -소화흡수율 향상 -축사 내 악취제거 |
사료에 1%이하 첨가 또는 급여 | |
| 펠릿형토양미생물제제 |
-토양개량 및 지력증진 - 기비효과 최적화 -토양유용미생물 밀도 증가 -토양 염류장해 개선 -작물 내병성 강화 -뿌리활력 촉진 |
10a당(300평) 60kg |
미생물 친환경 농업교육관
- 규 모 : 377.44㎡
- 주요시설 : 강의실, 소회의실, 실습실 등
![]() |
![]() |
구입방법
미생물 공급가격
| 구분 | 액상미생물제제 | 고형미생물제제 |
|---|---|---|
| 순천시민 및 순천시에 주소를 두고 있는 농업관련 영농법인 단체 (제 6조 제 1항) | 5ℓ/1,750 | 10kg/5,000 |
| 순천시에 주소 및 영업소를 두고 있는 법인 또는 단체 (제6조제2항) | 5ℓ/2,750 | 110kg/10,000 |
| 순천시민 이외의 자 (제6조제2항) | 5ℓ/5,500 | 10kg/15,000 |
구입절차
- 직접구입시
미생물 공급신청 → 고지서 입금(신용카드 결제) → 미생물제제 수령 - 배달제이용시
대      상 : 순천시 관내 전 지역
배달장소 : 읍면동 주민센터, 법인 및 기관단체
신청방법 : 전화신청 061) 749–8780
배달방법 : 주 1회 지역별 순회
- 월요일 : 서부권 (낙안면, 외서면, 송광면, 주암면)
- 화요일 : 남부권 (별량면, 상사면, 도사동, 해룡면)
- 수요일 : 북부권 (승주읍, 서면, 황전면, 월등면)
※ 배달 3일 전까지 전화신청 (액상은 50ℓ, 고형은 50kg이상 배달/1인1회)
※ 미생물 생산량과 배달물량에 따라 일정이 조정될 수 있음